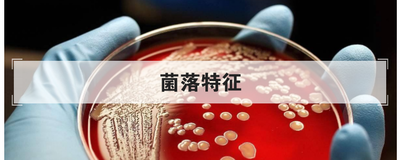
菌落特征
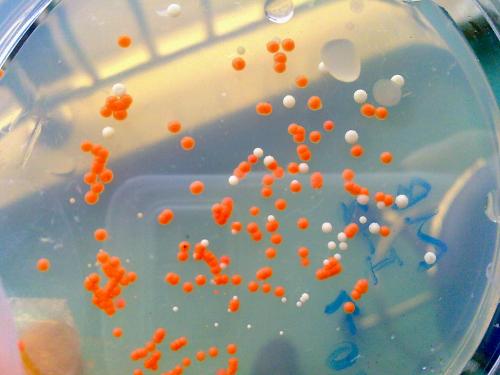
菌落特征
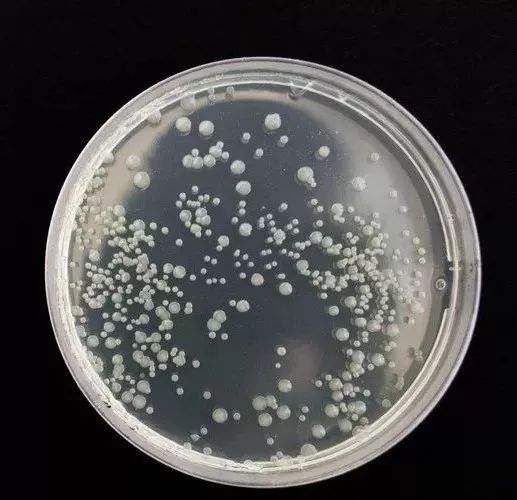
菌落特征
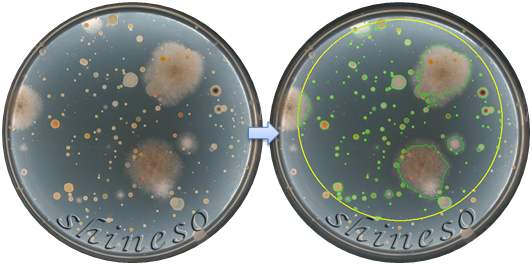
菌落特征

最佳回答
本文由作者推荐
简要回答
相信大家对菌落这个词并不陌生,在学习生物学的时候大家都了解过菌落,那么下面小编就来跟大家说一说菌落有什么特征。
详细内容
详细内容
- 01
菌落,是指由单个或少数微生物细胞在适宜固体培养基表面或内部生长繁殖到一定程度,形成以母细胞为中心的一团肉眼可见的、有一定形态、构造等特征的子细胞集团。通常是细菌在固体培养基上(内)生长发育,形成以母细胞为中心的一团肉眼可见的、有一定形态、构造等特征的子细胞的集团,称之为菌落。

- 02
各种微生物在一定条件下形成的菌落特征,如大小、形状、边缘、表面、质地、颜色等,具有一定的稳定性,是衡量菌种纯度、辨认和鉴定菌种的重要依据。菌落特征与微生物的菌体形态结构特征密切相关。

- 03
例如,细菌、酵母菌不形成菌丝,其菌落仅生长在固体培养基表面,与培养基结合不紧密,可用接种工具将其全部挑起;而放线菌、霉菌的菌体大多分化为营养菌丝与繁殖菌丝,营养菌丝深入培养基中吸取营养,具有与培养基结合较紧,不易挑起等特征。
- 04
菌落形态包括菌落的大小、形状、边缘、光泽、质地、颜色和透明程度等。每一种细菌在一定条件下形成固定的菌落特征。不同种或同种在不同的培养条件下,菌落特征是不同的。这些特征对菌种识别、鉴定有一定意义。
- 05
细胞形态是菌落形态的基础,菌落形态是细胞形态在群体集聚时的反映。细菌是原核微生物,故形成的菌落也小;细菌个体之间充满着水分,所以整个菌落显得湿润,易被接种环挑起;球菌形成隆起的菌落;有鞭毛细菌常形成边缘不规则的菌落;具有荚膜的菌落表面较透明,边缘光滑整齐;有芽孢的菌落表面干燥皱褶;有些能产生色素的细菌菌落还显出鲜艳的颜色。
广告位
点击排行
- 2 排行
- 3 排行
- 4 排行
- 5 排行
- 6 排行
- 7 排行
- 8 排行
- 9 排行
- 10 排行
广告位





















